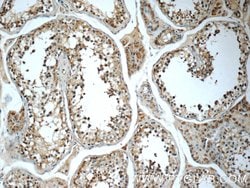
Cryptochrome 1 Rabbit anti-Human, Mouse, Rat, Polyclonal, Proteintech 150
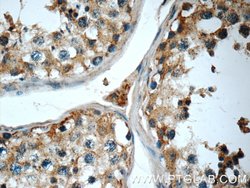
Cryptochrome 1 Rabbit anti-Human, Mouse, Rat, Polyclonal, Proteintech 150
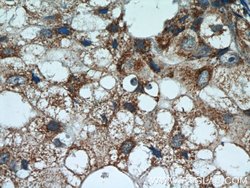
Cryptochrome 1 Rabbit anti-Human, Mouse, Rat, Polyclonal, Proteintech 150

Promotional price valid on web orders only. Your contract pricing may differ. Interested in signing up for a dedicated account number?
Learn More
Learn More
Cryptochrome 1 Rabbit anti-Human, Mouse, Rat, Polyclonal, Proteintech


Rabbit Polyclonal Antibody
Supplier: Proteintech Group Inc 134741AP150UL

Description
Various biochemical, physiological and behavioural processes display circadian rhythms controlled by an internal biological clock. The central "gears" driving this clock appear to be composed of an autoregulatory transcription/posttranslation-based feedback loop. Cryptochrome 1 (CRY1) and 2 (CRY2) are DNA-binding flavoproteins that bear some homology to blue-light receptors and photolyases. In Drosophila, CRY is a photoreceptor for the circadian clock where it binds to the clock component TIM in a light-dependent fashion and blocks its function. Mammalian CRY1 and CRY2 function via light-independent interactions with circadian genes CLOCK and BMAL1, as well as with PER1, PER2, and TIM. They seem to act as light-independent components of the circadian clock and likely regulate Per1 transcriptional cycling via interactions with both the activator and its feedback inhibitors. Mutant mice not expressing the Cry1 or Cry2 protein display accelerated and delayed periodicity of locomotor activity, respectively. It appears that the combination of both proteins working together is essential to synchronize the organism to circadian phases. A critical balance between Cry1 and Cry2 is required for proper clock function; in complete darkness, double-mutant mice present with instantaneous arrhythmicity, indicating the absence of an internal circadian clock.Specifications
| Cryptochrome 1 | |
| Polyclonal | |
| Unconjugated | |
| CRY1 | |
| CRY1, Cryptochrome 1, PHLL1 | |
| Rabbit | |
| Antigen Affinity Chromatography | |
| RUO | |
| 12952, 1407, 299691 | |
| -20°C | |
| Liquid |
| Immunocytochemistry, Immunofluorescence, Immunohistochemistry (Paraffin), Western Blot | |
| 0.19 mg/mL | |
| PBS with 50% glycerol and 0.02% sodium azide; pH 7.3 | |
| P97784, Q16526, Q32Q86 | |
| Cry1 | |
| Cryptochrome 1 Fusion Protein Ag4270 | |
| 150 μL | |
| Primary | |
| Human, Mouse, Rat | |
| Antibody | |
| IgG |
Product Content Correction
The Fisher Scientific Encompass Program offers items which are not part of our distribution portfolio. These products typically do not have pictures or detailed descriptions. However, we are committed to improving your shopping experience. Please use the form below to provide feedback related to the content on this product.
Product Title
Spot an opportunity for improvement?Share a Content Correction